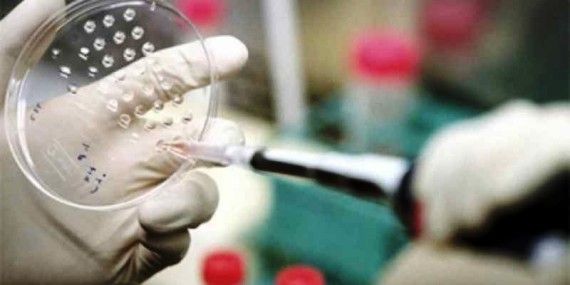

CIUDAD DE MÉXICO, 17 de Junio.- Las células del sistema inmunológico que se encuentran en los ganglios linfáticos podrían ayudar a desarrollar una vacuna contra el VIH, de acuerdo con un estudio del Centro de Investigación en Enfermedades Infecciosas (Cieni). La doctora Perla Mariana del Río Estrada indicó que conocer de manera precisa la reacción del sistema inmune ante el Virus de Inmunodeficiencia Humana (VIH) auxiliaría en la creación de una posible vacuna contra el virus.
“Solamente cinco por ciento de las células que nos protegen está en la sangre. El resto de las células se encuentra en el tejido linfoide, muchas de ellas en los ganglios linfáticos”, explicó la investigadora. En una entrevista con la Agencia Informativa del Consejo Nacional de Ciencia y Tecnología (Conacyt), del Río Estrada mencionó que se detectó que el VIH se oculta dentro de las células de los ganglios linfáticos, donde se replica aun si el paciente está en tratamiento.
Estudios previos demuestran que la respuesta inmunológica de los ganglios linfáticos, es la más asociada con la protección de una posible vacuna. El estudio de Cieni logró caracterizar todas las células que se pueden encontrar en los ganglios linfáticos, células dendríticas, células T (CD4, CD8 y reguladoras), células NK y células B.
“Los eventos más importantes para que tu organismo reaccione fuertemente o logre eliminar una infección ocurren en ese tejido, donde también viven células que no vamos a encontrar en la sangre”, mencionó del Río Estrada.
Dentro de los ganglios linfáticos están las células T foliculares, poblaciones de linfocitos B y de células dendríticas, las cuales solo están en ese tejido.
También, las células T foliculares, así como todas las demás T CD4, son afectadas por el VIH y usadas como depósito del virus en los linfáticos. La investigadora mencionó que debido a su anatomía, los ganglios linfáticos dejan organizar a las células en sitios específicos (microanatomía), lo que permite la cercanía y el contacto entre poblaciones de células que necesitan interactuar entre sí.
“Cuando se encuentran con un patógeno, las células se van moviendo de una microrregión a otra y crean contactos temporales con sus vecinas. Son esos contactos los que permiten que se genere la inmunidad adaptativa entre las células T y las células B, que son las que producen anticuerpos”, indicó.
“Luego se empiezan a acumular fibras de colágeno y suceden otras alteraciones, aparentemente esto impide que la respuesta inmunológica sea adecuada y que las células puedan tener ese contacto entre ellas o que se desplacen de un lado a otro”, añadió.
La vacuna se desarrollaría mediante las bases científicas a través de los conceptos de respuesta inmune innata y adaptativa, la primera ocurre de forma inmediata cuando las células reconocen patrones específicos en los agentes patógenos. Sin embargo, los agentes se comparten por grupos de patógenos, es decir, la característica de todas las bacterias o de los hongos o virus no son específicos para cada especie, explicó la doctora.
“La respuesta adaptativa va un paso más allá, si el primer armamento no funciona, la adaptativa reconoce características muy específicas, antígenos que solo tiene un microorganismo específico”, añadió. Tras el reconocimiento, la respuesta adaptativa genera una memoria inmunológica que al entrar de nuevo al cuerpo, el microorganismo es reconocido por un grupo de células específicas de este patógeno para atacarlo.
“La memoria de estas células del sistema inmune (células T y células B de memoria) son lo que nos permite generar vacunas, y estudiar su comportamiento ante la infección por VIH nos permite avanzar en este objetivo”, señaló la especialista.
En la investigación del Cieni colaboran laboratorios de Estados Unidos y otras partes del mundo, así como el Instituto Nacional de Salud de Estados Unidos (NIH, por sus siglas en inglés) y universidades de Pensilvania y Boston. (FUENTE: El informador)

Los comentarios están cerrados.